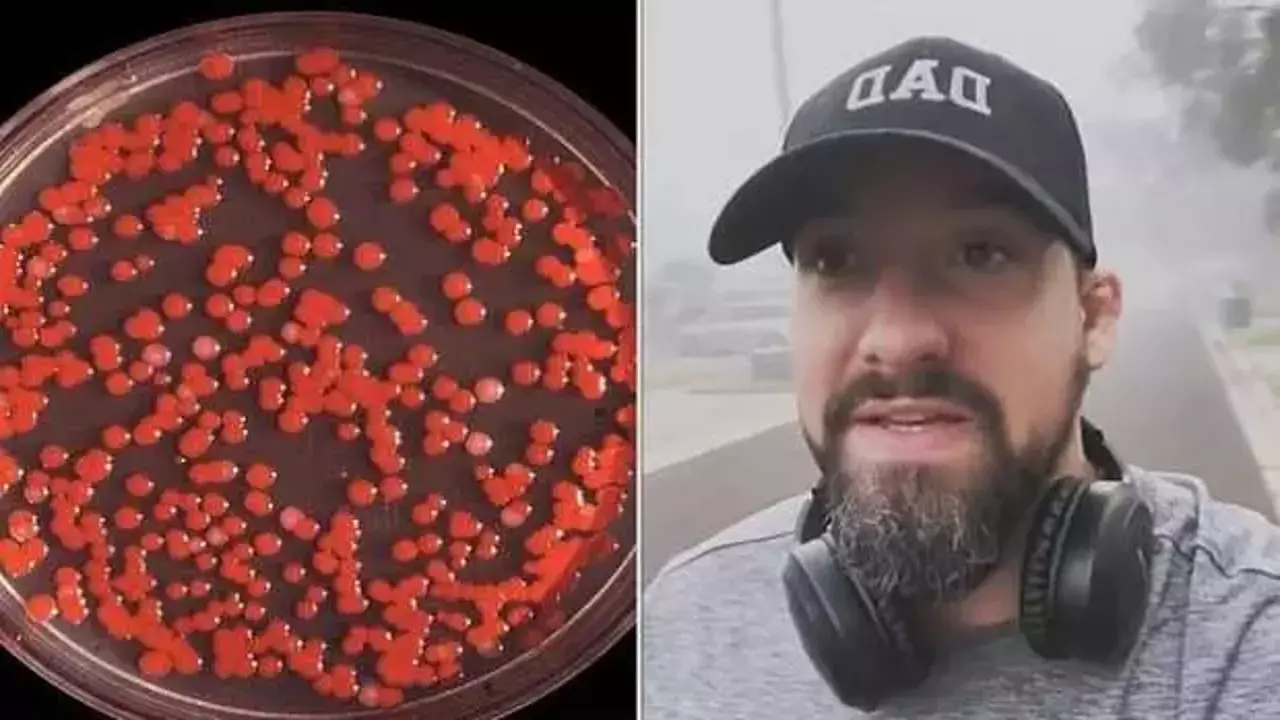

Amerika Birleşik Devletleri'nin bazı bölgelerinde görülen sis, özellikle Florida ve Kansas gibi yerlerde halk arasında korkuya yol açtı. Birçok kişi, sisin içinde kısa süre kaldıktan sonra hapşırma, göz şişmesi ve ateş yükselmesi gibi semptomlar yaşadığını belirtti. Bu durum, bölge sakinlerini paniğe sevk etti.

Kimyasal Sis Mi? Komplo Teorileri Artıyor
Sis, bazılarına göre sıradan bir hava olayı değil. Sosyal medyada, sisin kimyasal bir saldırı sonucu oluştuğuna dair komplo teorileri hızla yayıldı. "Kimyasal sis" adı verilen bu teoriler, özellikle sisin keskin kokusunun grip benzeri hastalıklara yol açtığı iddialarıyla güçlendi. Birçok kişi, "Fogvid-24" adlı bir hastalıkla ilişkilendirilen bu durumu tartışmaya açtı.

1950'teki Biyolojik Silah Deneyi Akıllara Geldi
Yaşanan olay, 1950 yılındaki Deniz Spreyi Operasyonu'nu hatırlattı. O dönemde ABD Donanması, San Francisco'yu biyolojik silahlarla test etmek amacıyla bakteriler püskürtmüştü. Bu operasyon, birkaç ölüm ve ciddi hastalıklara yol açmıştı. Bu benzerlik, bazı kişilerin biyolojik silah kullanımına dair teorilere daha fazla inanmasına neden oldu.

Sis Neden Oluşuyor?
Uzmanlar, sisin aslında bir hava olayı olduğunu belirtiyor. Sis, su damlacıkları veya buz kristallerinden oluşan bir buluttur. Sis, havanın doygunluk noktasına ulaşmasıyla oluşur. Bu süreç, biyo-silahlarla hiçbir ilgisi olmadığını vurgulayan uzmanlar, sisin doğal bir fenomen olduğunu belirtiyor.

Sisin Dünya Yüzeyine Çok Yakın Olması Kokuyu Ortaya Çıkartıyor
Daily Mail'in haberine göre, sisin dünya yüzeyine çok yakın olması nedeniyle, kirleticileri ve kokuları emmesi, bölge sakinlerinin neden keskin bir koku fark ettiklerini açıklayabilir. Bazı uzmanlara göre sis, havadaki yüksek nem seviyeleri nedeniyle solunum sorunlarına da neden olabilir. Sonbahar ve kış ayları, sisin oluştuğu yılın en yaygın zamanlarıdır ve bu da ülke genelinde bu fenomenin artışını açıklayabilir.
Bilimsel Açıklama Sis ve Sağlık Etkileri
Bilim insanları, sisin solunum sorunlarına yol açabileceğini ve özellikle sonbahar ve kış aylarında daha sık görüldüğünü belirtiyor. Yüksek nem oranları ve düşük sıcaklıklar, sisin oluşumunu destekler. Ancak bu fenomenin biyolojik silahlarla herhangi bir ilgisi bulunmamaktadır. Gizemli sis olayları, komplo teorilerini ve korkuları yeniden alevlendirmiş olsa da, bilimsel veriler, bunun tamamen doğal bir hava olayı olduğunu ortaya koyuyor. Sis ve kokuların sağlık üzerindeki etkileri ise, özellikle yüksek nem oranlarıyla ilişkilidir. Bu durum, halk arasında oluşan paniği yatıştırmak için önemli bir uyarı niteliği taşıyor.

























